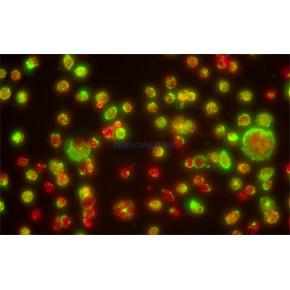
医院病理科 相差荧光显微镜配置方案

广州企业最新动态


赋能航空航天 + 半导体检测!JX-50M 国产金相显微镜成高端制造优选
伴随着国产高端制造的迅速发展,检测设备作为质控环节的关键力量,其性能和精度成为行业竞逐的焦点。广东启广东启亚检测设备股份有限公司2025-12-02

登尼特代办广州公司更名:专业高效,助力品牌升级一步到位
公司更名是企业品牌战略升级的关键一步,但涉及工商、税务、银行、商标等多部门协同,流程复杂且易因细节疏广州市登尼特企业顾问有限公司2025-12-02
明场 / 暗场 / 偏光全能适配,JX-50M 金相显微镜解锁多材料分析新方案
广东启亚检测设备股份有限公司近日推出了全新JX-50M金相显微镜,凭借明场、暗场和偏光三种光学模式的广东启亚检测设备股份有限公司2025-12-02


上门/到店系统:掘金夜间经济,打造24小时不打烊的健康服务平台(平台/app/源码)
传统按摩门店受制于营业时间,错过了庞大的夜间消费需求。我们的双模式系统,助您突破时空限制,掘金“夜间正诺(广州)信息科技有限公司2025-12-02
上门/到店系统:深耕社区经济,锁定家庭健康消费核心——宝妈与长者(系统/app/源码)
家庭消费是服务业的蓝海,而宝妈和长者则是其中的核心用户。他们往往因行动不便、需要居家照看家人而难以出正诺(广州)信息科技有限公司2025-12-02
0.001mm 微调精度 + 多档分光比!JX-50M 显微镜刷新工业检测精准度标准
在工业检测领域,精准度是衡量设备性能和检测质量的核心指标。广东启亚检测设备股份有限公司最新推出的JX广东启亚检测设备股份有限公司2025-12-02

上门/到店系统:都市白领的午休焕活与企业福利新赛道(软件/app/源码)
都市白领是“懒人经济”与“健康焦虑”的核心群体。他们时间宝贵,工作压力大,肩颈劳损问题普遍。我们的双正诺(广州)信息科技有限公司2025-12-02








灯具静态风力试验IEC 60598-2-5:2015解读
灯具静态风力试验IEC 60598-2-5:2015解读灯具静态风力试验IEC 60598-2-5:深圳市奥测电子技术服务有限公司佛山分公司2025-12-02

国产金相新突破!蔚仪 JX-50M 搭载 DIC 微分干涉系统,100X 倍率实现超高清观测
随着材料科学和制造技术的不断发展,对金相分析设备的性能要求也在逐步提高。近日,广东启亚检测设备股份有广东启亚检测设备股份有限公司2025-12-02

手持灯手电筒安全测试IEC 60598-2-8:2013标准介绍
手持灯手电筒安全测试IEC 60598-2-8:2013标准介绍手持灯手电筒作为便携式照明工具,其安深圳市奥测电子技术服务有限公司佛山分公司2025-12-02




灯具儿童防火防触电测试IEC 60598-2-10:2003标准解读
灯具儿童防火防触电测试IEC 60598-2-10:2003标准解读灯具儿童防火防触电测试IEC 6深圳市奥测电子技术服务有限公司佛山分公司2025-12-02















寄售模式商城逻辑软件开发平台小程序(源码搭建、APP、网站)
寄售模式商城逻辑技术开发方案选择定制化开发描述:从零开始,根据您的业务需求进行设计和编码恒探软件网络科技(6年开发公司)2025-12-02





寄售模式商城逻辑系统APP开发(平台搭建、独立源码、网站)
寄售模式商城逻辑系统核心功能模块一个成熟的联营寄售模式商城逻辑,需要包含以下三大端的功能:1.&nb恒探软件网络科技(6年开发公司)2025-12-02










市场拓展篇——打造本地化服务标准,提升用户体验(软件、源码、产品)
海外用户对服务标准要求高,简单照搬国内模式难以成功。海外上门/到家系统结合当地法规与文化习惯,制定本正诺(广州)信息科技有限公司2025-12-02


市场拓展篇——应对汇率波动,稳定海外收益(APP、源码、平台)
跨境经营面临汇率波动风险,影响平台收益稳定性。海外上门/到家系统通过“多币种结算+数字货币对冲”机制正诺(广州)信息科技有限公司2025-12-02
市场拓展篇——把握节日经济,引爆海外订单高峰(软件、源码、产品)
春节、中秋等中国传统节日,是海外华人情感最浓烈的时刻,也是健康服务需求的爆发期。海外上门/到家系统提正诺(广州)信息科技有限公司2025-12-02



市场拓展篇——轻资产模式加速全球复制(系统、软件、平台)
海外上门/到家系统采用“平台+合伙人”轻资产模式,实现快速市场扩张。系统提供完整源码、运营后台、支付正诺(广州)信息科技有限公司2025-12-02



市场拓展篇——从华人圈层到主流社会的破圈之路(APP、源码、平台)
起初,海外上门/到家系统主要服务于华人社群。但随着口碑传播与支付方式的国际化,越来越多非华裔用户开始正诺(广州)信息科技有限公司2025-12-02















境外投资风险看不清?登尼特专业安全评估报告,为您扫清迷雾。
在全球化浪潮下,企业境外投资面临政策监管趋严、合规风险加剧的挑战。据商务部数据,2023年我国约15广州市登尼特企业顾问有限公司2025-12-02


规避风险,稳妥出海 | 登尼特一站式代办境外投资安全评估
在全球化浪潮下,企业境外投资面临政策监管趋严、合规风险加剧的挑战。据商务部数据,2023年我国约15广州市登尼特企业顾问有限公司2025-12-02
亚马逊平台LED灯带FCC SDoC认证内容解读
亚马逊平台LED灯带FCC SDoC认证内容解读为什么灯带需要申请FCC认证?美国联邦通信委员会(F深圳市奥测电子技术服务有限公司佛山分公司2025-12-02

亚马逊平台LED壁灯FCC SDoC认证流程介绍
亚马逊平台LED壁灯FCC SDoC认证流程介绍壁灯FCC认证办理:认证类型明确壁灯FCC认证办理:深圳市奥测电子技术服务有限公司佛山分公司2025-12-02

亚马逊美国站LED射灯FCC SDoC认证如何办理
亚马逊美国站LED射灯FCC SDoC认证如何办理射灯FCC认证办理:FCC认证的核心意义射灯FCC深圳市奥测电子技术服务有限公司佛山分公司2025-12-02
相关广州企业动态
- 广州某重点管道沉降及水平位移观测 第三方检测中心
- 广州高压绝缘器具年检检测(预防性试验)
- 2026中国家博会CIFF广州「链新」实验室|集体居住空间,如何从“有得住”走向“住得好”?
- 广州门座式起重机安装许可证详细办理流程及资料
- 2026广州春季美博会|广州琶洲化妆品展览会|广东第69届化妆品美博会
- 广州TNT快递清关代理|检验检疫|查验放行
- 广州左右移动停车位 俯仰式机械停车场可过验收 自走立体车库翻新厂家
- 广州展台设计 广州展厅设计搭建商:展台设计搭建布置
- 广州到伊拉克海运 伊拉克海运需要多久
- 2026广州国际美博会-2026年3月广州美博会
- 广州奶茶原料海运进口一对一跟进
- 广州明慧供应相差荧光显微镜安徽-MHIF2000
- 广州指标入户,快速的入户方式,三无人员均可办理!
- 2026全国跨境电商展——广州跨境电商展览会
- 塑胶粒海运鉴定 广州货物运输报告专注出具
- 广州到伊拉克海运包税到门 广州到伊拉克海运双清物流的操
- 广州长途救护车出租-非急救转运服务-覆盖全国主要城市
- 广州开公司,专业的事交给登尼特 – 让创业更简单
- 转让北京会计师事务所带人员 河南会计师事务所 天津会计师事务所 广州会计师事务所
- 2026广州太阳能光伏展·光伏生产设备产业链展












































